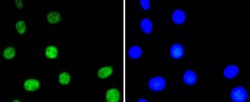
Invitrogen Phospho-ATF2 (Thr71) Recombinant Rabbit Monoclonal Antibody
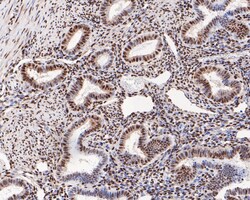
Invitrogen Phospho-ATF2 (Thr71) Recombinant Rabbit Monoclonal Antibody

Learn More
Invitrogen™ Phospho-ATF2 (Thr71) Recombinant Rabbit Monoclonal Antibody (SC05-90)


Rabbit Recombinant Monoclonal Antibody
Brand: Invitrogen™ MA532204
Description
Recombinant rabbit monoclonal antibodies are produced using in vitro expression systems. The expression systems are developed by cloning in the specific antibody DNA sequences from immunoreactive rabbits. Then, individual clones are screened to select the best candidates for production. The advantages of using recombinant rabbit monoclonal antibodies include: better specificity and sensitivity, lot-to-lot consistency, animal origin-free formulations, and broader immunoreactivity to diverse targets due to larger rabbit immune repertoire.
The transcription factor ATF-2 (also called CRE-BP1) binds to both AP-1 and CRE DNA response elements and is a member of the ATF/CREB family of leucine zipper proteins. ATF-2 interacts with a variety of viral oncoproteins and cellular tumor suppressors and is a target of the SAPK/JNK and p38 MAP kinase signaling pathways. Various forms of cellular stress, including genotoxic agents, inflammatory cytokines and UV irradiation, stimulate the transcriptional activity of ATF-2. Cellular stress activates ATF-2 by phosphorylation of Thr69 and Thr71. Both SAPK and p38 MAPK have been shown to phosphorylate ATF-2 at these sites in vitro and in cells transfected with ATF-2.
Specifications
| Phospho-ATF2 (Thr71) | |
| Recombinant Monoclonal | |
| 1 mg/mL | |
| TBS with 0.05% BSA, 40% Glycerol and 0.05% sodium azide; pH 7.4 | |
| P15336 | |
| Atf2 | |
| Synthetic phospho-peptide corresponding to residues surrounding Thr71 of Human ATF2 aa 58-94. | |
| 100 μL | |
| Primary | |
| Human | |
| Antibody | |
| IgG |
| Immunohistochemistry (Paraffin), Western Blot, Immunocytochemistry | |
| SC05-90 | |
| Unconjugated | |
| Atf2 | |
| Activating 2; Activating transcription factor 2; activating transcription factor 2 splice variant ATF2-var2; ATF2; Atf-2; cAMP response element-binding protein CRE-BP1; cAMP responsive element binding protein 2, formerly; cAMP-dependent transcription factor ATF-2; CREB2; CREB-2; CRE-BP; CREBP1; CRE-BP1; Cyclic AMP-dependent transcription factor ATF-2; cyclic AMP-responsive element-binding protein 2; D130078H02Rik; D18875; HB16; Histone acetyltransferase ATF2; MGC111558; mXBP; MXBP protein; OTTHUMP00000205345; OTTHUMP00000205347; OTTHUMP00000205348; OTTHUMP00000205350; OTTHUMP00000205352; OTTHUMP00000205353; OTTHUMP00000205354; Tg(Gzma-Klra1)7Wum; TREB7 | |
| Rabbit | |
| Protein A | |
| RUO | |
| 1386 | |
| Store at 4°C short term. For long term storage, store at -20°C, avoiding freeze/thaw cycles. | |
| Liquid |
Your input is important to us. Please complete this form to provide feedback related to the content on this product.